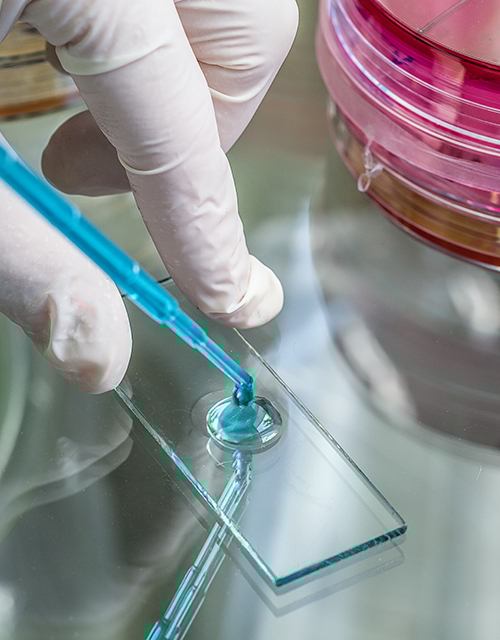

ISSO 55.1 en InfoDWI
Het Instituut voor Studie en Stimulering van Onderzoek op het gebied van gebouwinstallaties (ISSO) en het informatieplatform van de drinkwaterbedrijven InfoDWI voorzien vakmensen van kennis, zodat ze kunnen zorgen voor gezonde, veilige en duurzame gebouwen.